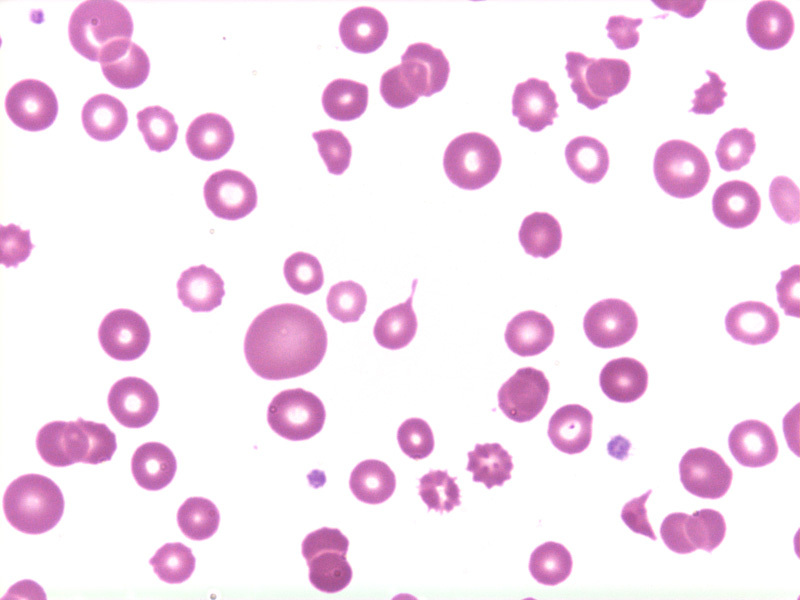

Aplastic Anemia
Overview
Aplastic Anemia
Etiologies
Fanconi’s Anemia
AR trait
Associated with:
Aplastic Anemia
Clinical Manifestations
Aplastic Anemia
Diagnosis
Aplastic Anemia
Treatment
Pure Red Cell Aplasia
Myelophthisic Anemia
Myelodysplastic Syndromes (MDS)
Overview

Myelodysplastic Syndromes (MDS)
Secondary Causes
Myelodysplastic Syndromes (MDS)
Clinical Manifestations
Myelodysplastic Syndromes (MDS)
Pathology

Myelodysplastic Syndromes (MDS)
FAB Classification
Chronic Myelomonocytic Leukemia (CMML)
Myelodysplastic Syndromes (MDS)
Chromosomal Abnormalities
Most common:
Myelodysplastic Syndromes (MDS)
Treatment
Myeloproliferative Neoplasms
(MPN)

Polycythemia Vera

Secondary Polycythemia
Caused by ↑ erythropoietin
Polycythemia Vera
Criteria
Polycythemia Vera
Clinical Manifestations
Polycythemia Vera
Prognosis
Polycythemia Vera
Complications
Polycythemia Vera
Treatment